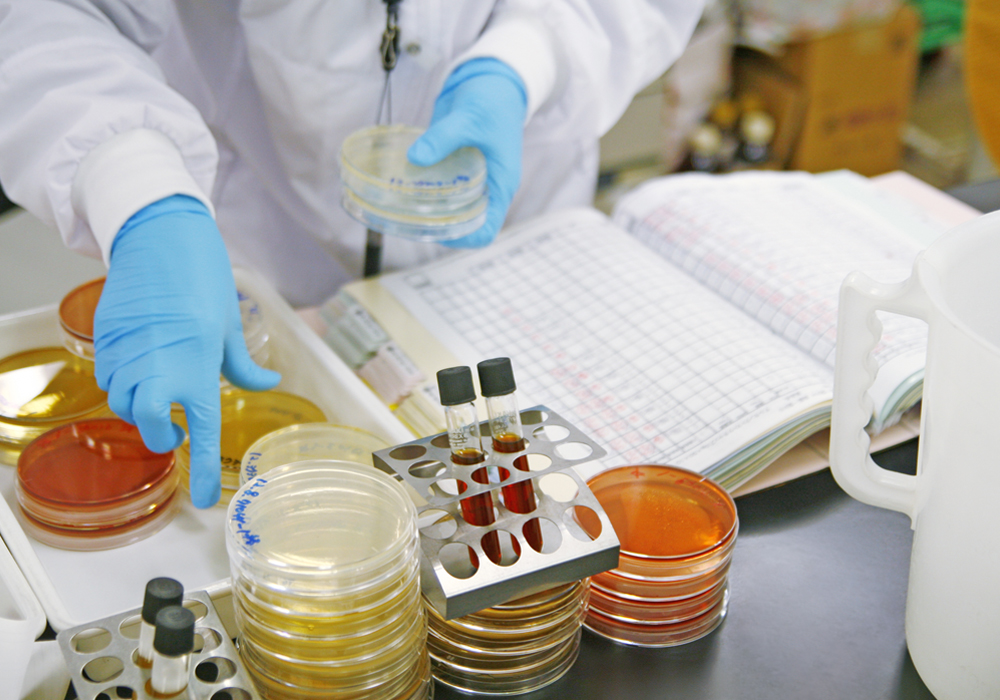

… 技術系 …
Work
製造部門
宝醤油の”おいしい”を支える製造エンジニア
~Work01~
●原材料の受け入れ・計量・仕込み、調味料の混合・加熱・冷却工程の管理
●製品の充填・包装作業
●製造機械の操作、保守や簡単なメンテナンス
●品質検査(味・外観・重量など)と記録
●作業場の衛生管理・清掃 ●生産効率向上のための改善活動(エンジニアリング業務)
たれ・つゆ・から揚げ粉などの製造工程を担当します。原材料の計量・仕込みから加熱・混合、充填・包装まで、品質と安全を守りながら製品を仕上げます。さらに、製造設備の操作やメンテナンス、効率化のための改善活動など、エンジニアリングの要素も含まれ、現場の安定稼働と生産性向上を支える需要な役割を担っております。
開発部門
宝醤油の「味」をつくるクリエイター
~Work02~
●新商品の企画・レシピ開発
●顧客や営業部門との打ち合わせ、ヒアリング
●試作・官能評価
●原材料の選定・配合調整
●量産化対応に向けた製造ラインへの落とし込み ●法令・規格に基づく表示確認、書類作成
スーパーマーケットやコンビニ惣菜、飲食店や食品メーカー向けの新しい調味料(たれ・つゆ、から揚げ粉など)の企画・試作・改良を行います。市場のニーズや顧客の要望に応え、オリジナルの味を形にするクリエイティブな仕事です。特に、顧客との共同開発を通じて、オンリーワンの商品を生み出すことができます。営業部、製造部、品質管理部などと連携しながら、商品化までのプロセスをリードします。
生産管理部門
工場の流れを操る司令塔
~Work03~
●生産計画の作成・進捗管理
●原材料・資材の発注・在庫管理
●製造ラインの稼働状況の確認・調整
●納期管理と出荷スケジュールの調整 ●コスト管理と生産効率の改善提案 ●製造部・品質管理部との連携
製造計画の立案から原材料の調達、在庫管理、納期管理まで、製造現場を円滑に動かすための指令としての役割を持っています。効率的な生産体制を構築し、品質・コスト・納期を守ることで、安定した供給を実現する重要な仕事です。
品質保証部門
安全と安心で信頼を守るスペシャリスト
~Work04~
●製品の品質保証業務全般
●法令・規格に基づく表示確認、書類作成
●製造工程や品質管理体制の監査・改善
●顧客からの品質問い合わせ対応
●クレーム発生時の原因調査・再発防止策の立案 ●FSSCなどの認証維持・更新業務
製品の品質を保証し、顧客や会社からの信頼を守る部門です。法令や規格に基づく管理体制の構築、製造工程の監査、顧客対応など、品質に関する幅広い業務を担当します。
品質管理部門
品質のプロとして、安全を届ける
~Work05~
●製品の品質検査
●異物混入防止のためのチェック
●工場内の衛生管理・清掃確認
●検査結果の記録・報告
●品質基準に基づく工程確認 ●品質向上のための改善活動の提案
製品の安全性と品質を守るために、製造工程や完成品の検査を行います。味・外観・重量などの品質チェック、異物混入防止、工場内の衛生管理を徹底し、検査結果を記録・報告します。また、品質トラブルの原因分析や再発防止策を提案し、現場改善に貢献します。